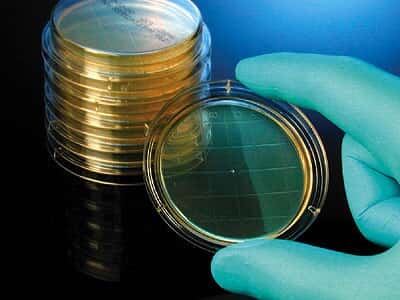
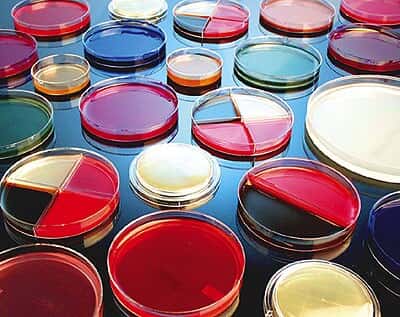

Cole-Parmer 검색
Cole-Parmer의 전 상품을 검색하실 수 있습니다.

- 번호
-
- Cat. No
- Model
- Description
- Unit
- Price(VAT별도)
- 재고
- 주문
- 55296

- CO.1420100
- 14201-00
- SPREADER 500/PK
- 1/PK
- 문의
- 15 Day

- 55295

- CO.1420101
- 14201-01
- CEL SPREDR L-SHAPE INDV 100/CS
- 1/CS
- 소비자가 : 239,500원
- 15 Day

- 55294

- CO.1420102
- 14201-02
- CEL SPREDR L-SHAP 10PKS 500/CS
- 1/CS
- 소비자가 : 407,900원
- 15 Day

- 55293

- CO.1420110
- 14201-10
- SPREADER INDIV.WRAP 500/PK
- 1/PK
- 문의
- 15 Day

- 55292

- CO.1420120
- 14201-20
- PLATE TSA W/LECITHIN & TWEEN80/Contact plate, TSA with Lecithin and Tween 80, 10/pk/
- 1/EA
- 소비자가 : 76,800원
- 15 Day

- 55291

- CO.1420124
- 14201-24
- PLATE SABDEX W/LEC & TWEEN 80/Contact Plate, SabDex Agar, Friction Lid, for Surface Testing; 10/Pk/
- 1/EA
- 소비자가 : 110,700원
- 15 Day

- 55290

- CO.1420128
- 14201-28
- PLATE BLOOD AGAR 5%/Contact Culture Media Plate, Blood agar, 5%, 10/pk/
- 1/EA
- 소비자가 : 124,500원
- 15 Day

- 55289
- CO.1420132
- 14201-32
- PLATE EOSIN METHYLENE BLUE EMB/Contact plate, Eosin Methylene Blue, EMB, 10/pk/
- 1/EA
- 소비자가 : 73,300원
- 15 Day

- 55288

- CO.1420134
- 14201-34
- PLATE MANNITOL SALT AGAR/Contact plate, Mannitol Salt Agar, 10/pk/
- 1/EA
- 문의
- 15 Day

- 55287

- CO.1420136
- 14201-36
- PLATE ROSE BENGAL AGAR/Contact Culture Media Plate, Rose Bengal agar, 10/pk/
- 1/EA
- 문의
- 15 Day

- 55286

- CO.1420138
- 14201-38
- PLATE R2A AGAR min 10 bags/Contact Culture Media Plate R2A agar min 10/pk/
- 1/EA
- 문의
- 15 Day

- 55285

- CO.1420142
- 14201-42
- AGAR PLATE TSA/Prepared Culture Media Plate, Triptic Soy Agar (TSA), 10/pk/
- 1/PK
- 소비자가 : 38,900원
- 15 Day

- 55284

- CO.1420144
- 14201-44
- AGAR PLATE STANDAD METHODS/Prepared agar plate, Standard Methods agar, 10/pk/
- 1/PK
- 소비자가 : 44,500원
- 15 Day

- 55283

- CO.1420148
- 14201-48
- AGAR PLATE BAIRD PARKER/Prepared agar plate, Baird Parker agar, 10/pk/
- 1/PK
- 소비자가 : 68,000원
- 15 Day

- 55282
- CO.1420152
- 14201-52
- AGAR PLATE PDA(POTATO DEXTRS)/Prepared agar plate, PDA (potato dextrose agar), 10/pk/
- 1/PK
- 소비자가 : 84,700원
- 15 Day

- 55281

- CO.1420156
- 14201-56
- AGAR PLATE HEKTOEN ENTERIC/Prepared agar plate, HE enteric agar, 10/pk/
- 1/PK
- 소비자가 : 48,500원
- 15 Day

- 55280

- CO.1420158
- 14201-58
- AGAR PLATE MAC W/SORBITAL/Prepared agar plate, MacConkey agar with sorbital, 10/pk/
- 1/PK
- 소비자가 : 64,600원
- 15 Day

- 55279

- CO.1420162
- 14201-62
- CENTRIMIDE AGAR PLATE 10/PK/Prepared media plates, Centrimide agar, 10/pk/
- 1/PK
- 소비자가 : 91,100원
- 15 Day

- 55278

- CO.1420166
- 14201-66
- LAURYL TRYPTOSE BROTH PLATE/Prepared media tube, Lauryl Tryptose broth, 20 x 10 mL tube/
- 1/PK
- 소비자가 : 192,200원
- 15 Day

- 55277

- CO.1420168
- 14201-68
- LACTOSE BROTH 12X90ML BT/Lactose Broth, prepared; 90 mL bottle, 12/pk/
- 1/PK
- 문의
- 15 Day

- 55276

- CO.1420200
- 14202-00
- AZIDE DEXTROSE BROTH 500G/Dehydrated Culture Media, Azide Dextrose broth, 500 g/
- 1/EA
- 문의
- 15 Day

- 55275

- CO.1420201
- 14202-01
- BAIRD PARKER AGAR BASE 500G/Dehydrated Culture Media, Baird Parker agar, 500 g/
- 1/EA
- 문의
- 15 Day

- 55274

- CO.1420202
- 14202-02
- BLOOD AGAR BASE/LOW PH 500G/Blood Agar Base with Low pH, 500 g/
- 1/EA
- 소비자가 : 391,600원
- 15 Day

- 55273

- CO.1420203
- 14202-03
- AGAR BILE ESCULIN 500G 1/EA/Dehydrated Culture Media, Bile Esculin agar, 500 g/
- 1/EA
- 소비자가 : 440,200원
- 15 Day

- 55272

- CO.1420205
- 14202-05
- BRAIN HEART INFUSE BROTH 500/Brain Heart Infusion Broth, 500 g/
- 1/EA
- 문의
- 15 Day

- 55271

- CO.1420208
- 14202-08
- BUFFERED PEPTONE WATER 500G/Buffered Peptone Water, 500 g/
- 1/EA
- 소비자가 : 197,200원
- 15 Day

- 55270

- CO.1420211
- 14202-11
- D/E NEUTRALIZING BROTH 500G/D/E neutralizing Broth, 500g/bottle/
- 1/EA
- 소비자가 : 192,200원
- 15 Day

- 55269

- CO.1420212
- 14202-12
- EC MEDIUM 500G/Dehydrated Culture Media, EC broth, 500 g/
- 1/EA
- 소비자가 : 461,600원
- 15 Day

- 55268

- CO.1420214
- 14202-14
- EOSIN METHYLENE BLUE AGAR 500/Eosin Methylene Blue Agar, Levine, 500 g/
- 1/EA
- 소비자가 : 263,600원
- 15 Day

- 55267

- CO.1420216
- 14202-16
- FLUID THIOGLYCOLLATE 500G/Fluid Thioglycollate Medium, 500 g/
- 1/EA
- 소비자가 : 261,100원
- 15 Day
